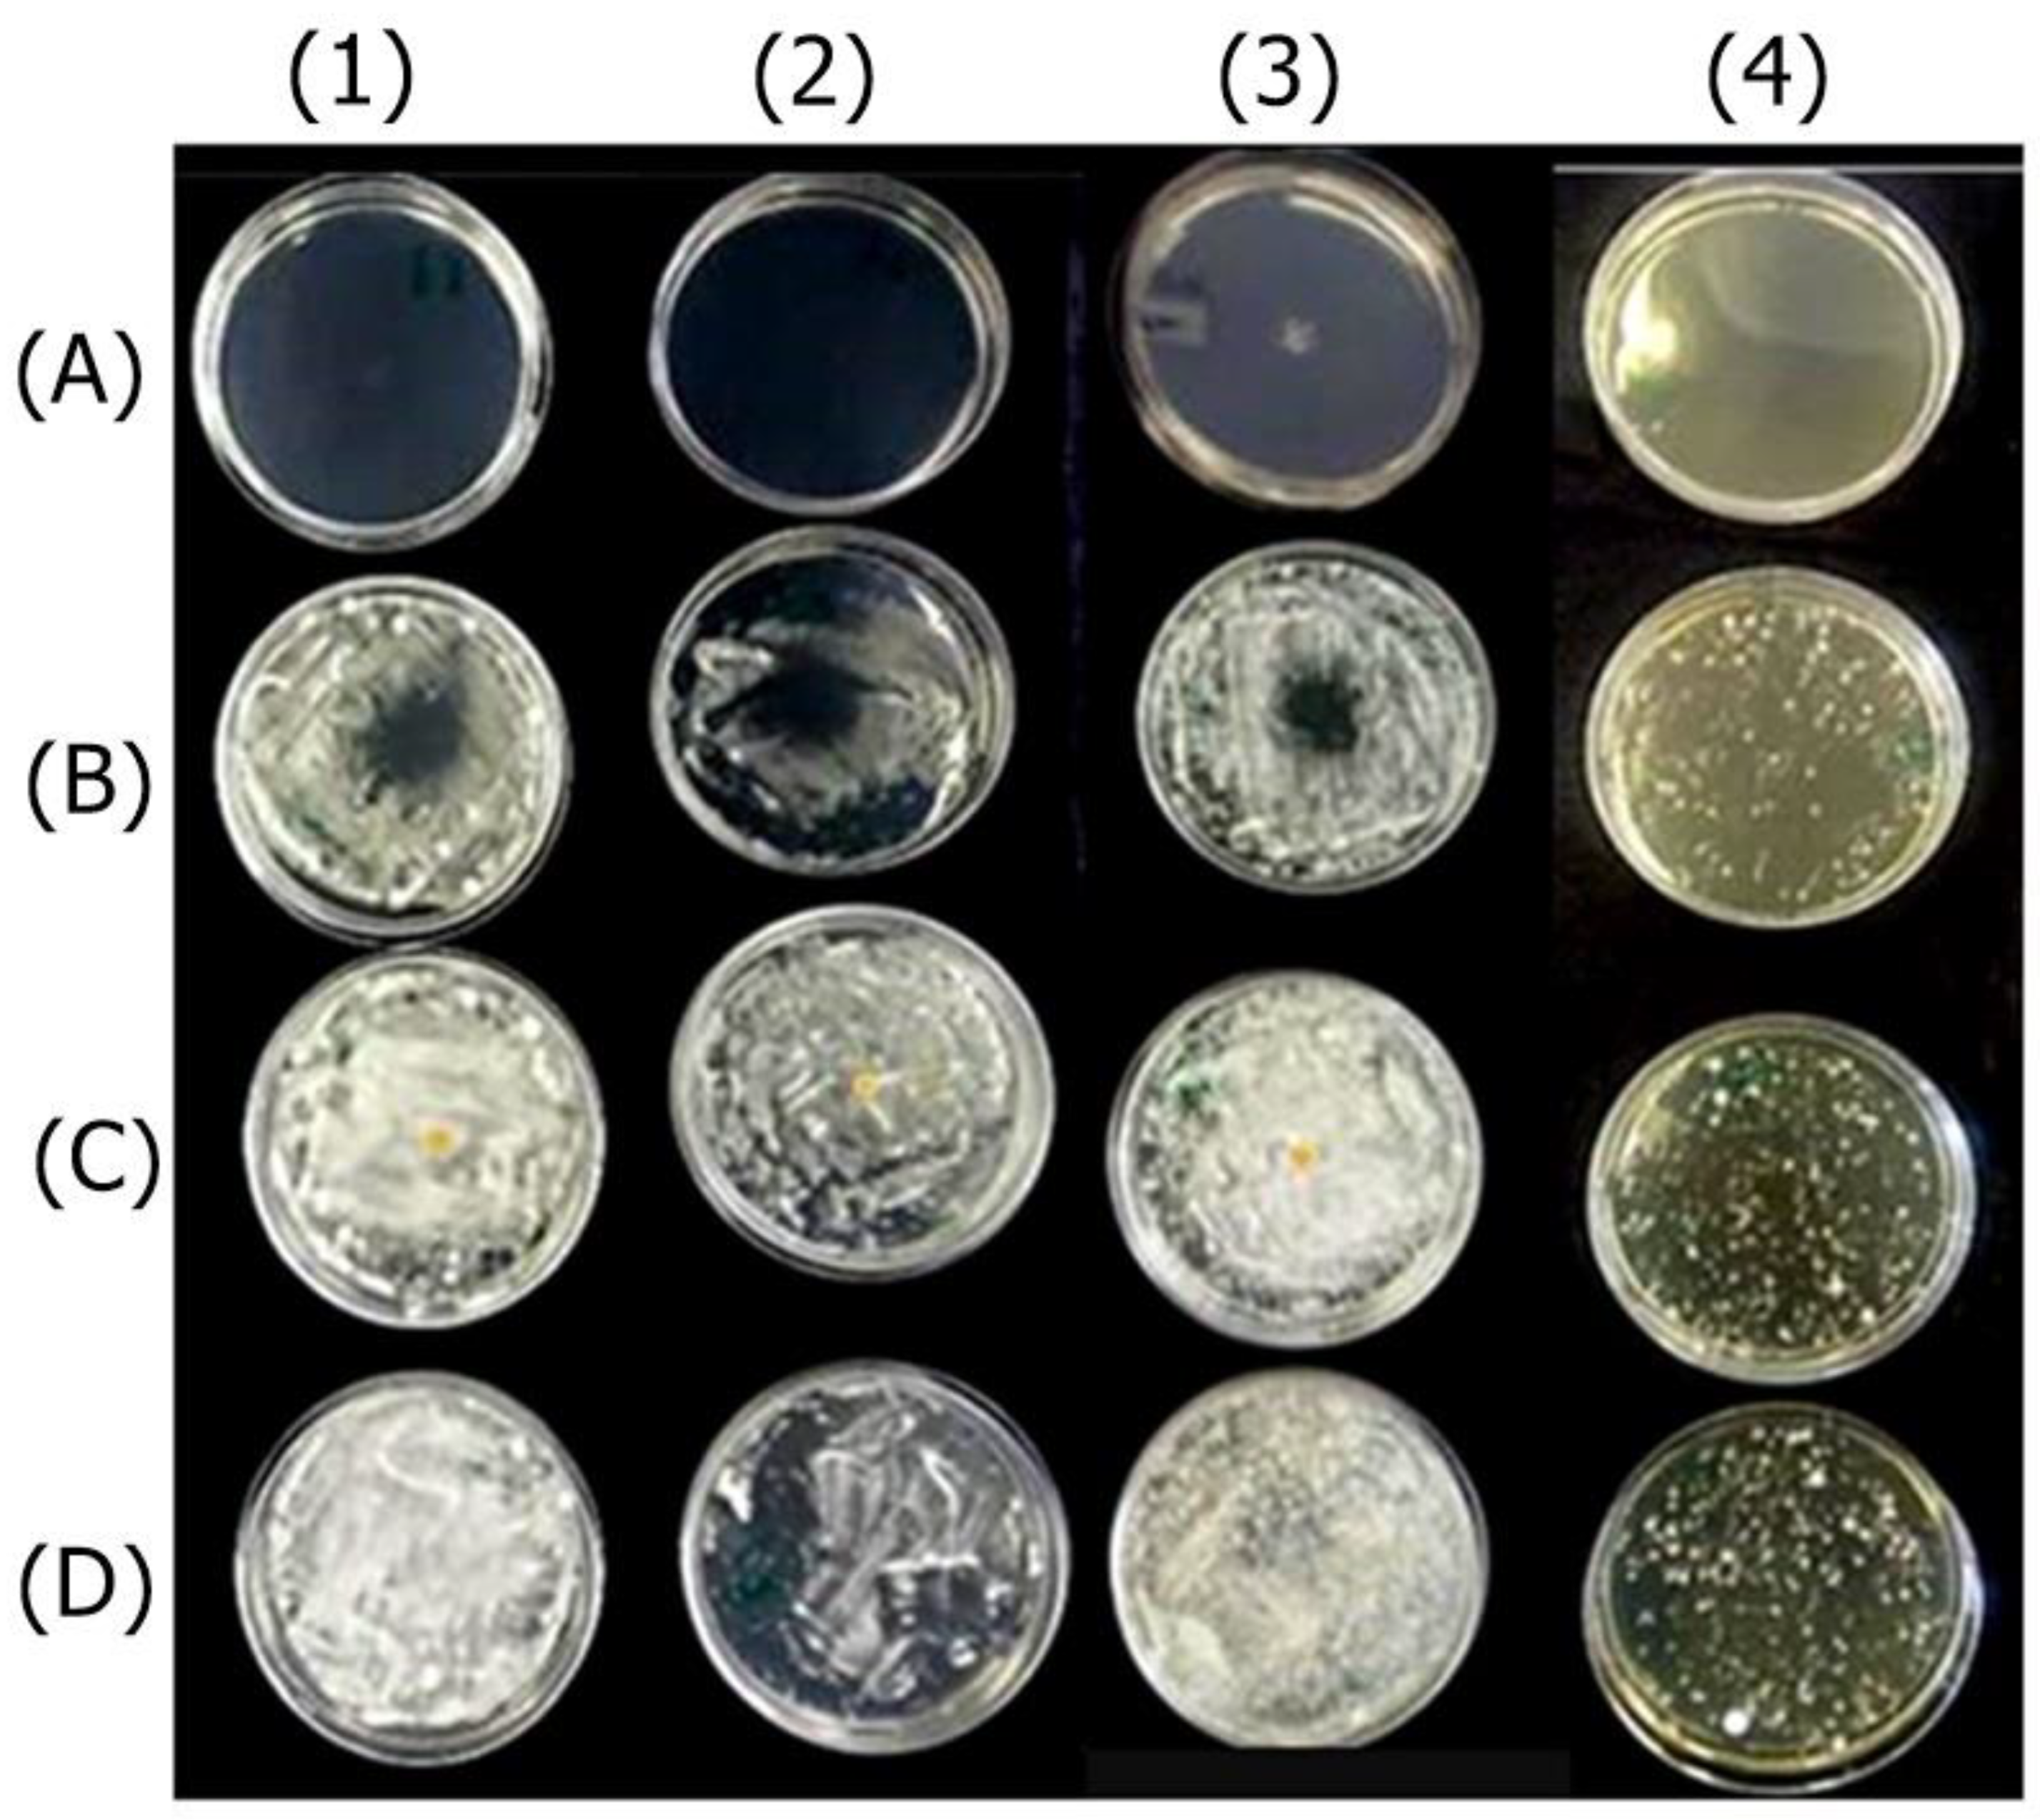
Preprints 115679 g001

Submitted:
19 August 2024
Posted:
22 August 2024
You are already at the latest version
Abstract

Keywords:
1. Introduction
2. Results
2.1. Study of the Active Ingredients
2.1.1. Antifungal Effect by Agar Diffusion Technique
2.1.2. Minimum Inhibitory and Minimum Fungicide Concentrations
2.1.3. Cytotoxicity Evaluation
2.2. Study of the Nail Lacquer Formulations
2.2.1. Antifungal Effect by Agar Diffusion Technique

2.2.2. Ex Vivo Antifungal Effect
2.2.3. Ex Vivo Permeation
2.2.4. Selection of The Best Nail Lacquer Formulations
2.2.4. Pharmacotechnical Characterization of the Selected Formulations: Centrifugation Test, Organoleptic Characteristics, pH, Density, and Drying Time
| Pharmacotechnical characteristics | F-OEO | F-OEO + Ag | BF |
|---|---|---|---|
| Centrifuge test | NPSP | NPSP | NPSP |
| Aspect | homogeneous liquid | homogeneous liquid | homogeneous liquid |
| Color | slightly yellowish | brown | colorless |
| Odor | OEO | OEO | ethyl acetate |
| pH | 4.0 | 4.4 | 4.4 |
| Density (g/cm3) | 9.99 ± 0.07 | 10.1 ± 0.01 | 9.91 ± 0.004 |
| Drying time (s) | 59.45 ± 1.98 | 90.30 ± 7.81 | 74.06 ± 2.21 |
2.2.5. Preliminary Stability Study
2.2.6. Antifungal Efficacy shown by Scanning Electron Microscopy
3. Discussion
4. Materials and Methods
4.1. Antifungal Agents
4.1.1. Essential Oils
4.1.2. Biogenically Synthetized Silver Nanoparticles (bioAgNP)
4.2. Development of Nail Lacquer Formulations
| Formulations | OEO | REO | bioAgNP |
|---|---|---|---|
| F-OEO | 7 | - | - |
| F-REO | - | 7 | - |
| F-Ag | - | - | 2.5 |
| F-OEO/REO | 3.5 | 3.5 | - |
| F-REO/Ag | - | 3.5 | 1.25 |
| F-OEO/Ag | 3.5 | - | 1.25 |
| F-OEO/REO/Ag | 2.33 | 2.33 | 0.83 |
| BF | - | - | - |
4.3. Pharmacotechnical Characterization of Nail lacquer Formulations
4.3.1. Pre-Stability Study
4.3.2. Organoleptic Characterization
4.3.3. Physicochemical Characterization
4.3.4. Determination of Film Drying Time
4.3.5. Preliminary Stability Study
4.4. Antifungal Activity of Actives and Nail Lacquer Formulations
4.4.1. Fungal Species
4.4.2. Analysis of Antifungal Activity of Actives and Formulations by Disk Diffusion Method
4.4.3. Determination of Minimum Inhibitory Concentration of the Actives
4.4.4. Determination of Minimum Fungicidal Concentration (MFC) of the Actives
4.4.5. Ex Vivo Evaluation of Antifungal Efficacy of the Nail Lacquer Formulations
4.4.6. Investigation of Antifungal Lacquer Efficacy by Scanning Electron Microscopy
4.5. Analysis of Nail lacquer Permeation
4.6. Cytotoxicity Assay of Antifungal Actives
4.7. Statistical Analysis
4.8. Experimental Design
5. Conclusion
Supplementary Materials
Author Contributions
Funding
Data Availability Statement
Acknowledgments
Conflicts of Interest
References
- Baswan, S.; Kasting, G.B.; Li, S.K.; Wickett, R.; Adams, B.; Eurich, S.; Schamper, R. Understanding the Formidable Nail Barrier: A Review of the Nail Microstructure, Composition and Diseases. Mycoses 2017, 60, 284–295. [Google Scholar] [CrossRef]
- Lee, D.K.; Lipner, S.R. Optimal Diagnosis and Management of Common Nail Disorders. Ann Med 2022, 54, 694–712. [Google Scholar] [CrossRef] [PubMed]
- Lee, D.K.; Lipner, S.R. Optimal Diagnosis and Management of Common Nail Disorders. Ann Med 2022, 54, 694–712. [Google Scholar] [CrossRef] [PubMed]
- Leung, A.K.C.; Lam, J.M.; Leong, K.F.; Hon, K.L.; Barankin, B.; Leung, A.A.M.; Wong, A.H.C. Onychomycosis: An Updated Review. Recent Pat Inflamm Allergy Drug Discov 2019, 14, 32–45. [Google Scholar] [CrossRef]
- Bodman, M.A.; Syed, H.A.; Krishnamurthy, K.
- Chen, K.L. Histopathologic Characterization of Onychomycosis in Nailbiopsies: A Retrospective Case Series of 19 Patients. J Cutan Pathol. 2023, 50, 103–105. [Google Scholar] [CrossRef] [PubMed]
- Bodman, M.A.; Syed, H.A.; Krishnamurthy, K. Onychomycosis Available online:. Available online: https://www.ncbi.nlm.nih.gov/books/NBK441853/ (accessed on 30 July 2024).
- Hong, J.-S.; Suh, M.-K.; Lee, K. A Study of the Quality of Life in Patients with Toenail Onychomycosis. Korean Journal of Dermatology 2019, 433–440. [Google Scholar]
- Tosti, A.; Vlahovic, T.C.; Arenas, R. Onychomycosis: An Illustrated Guide to Diagnosis and Treatment. 2017. [Google Scholar]
- Lee, D.K.; Lipner, S.R. Optimal Diagnosis and Management of Common Nail Disorders. Ann Med 2022, 54, 694–712. [Google Scholar] [CrossRef]
- Sajeed, M.; Wei, L.; Murdan, S. What Can GP Data Tell Us about the Treatment of Onychomycosis in the UK? Skin Health and Disease 2022, 2. [Google Scholar] [CrossRef]
- Gupta, A.K.; Venkataraman, M.; Renaud, H.J.; Summerbell, R.; Shear, N.H.; Piguet, V. A Paradigm Shift in the Treatment and Management of Onychomycosis. Skin Appendage Disord 2021, 7, 351–358. [Google Scholar] [CrossRef]
- Guinea, J. New Trends in Antifungal Treatment: What Is Coming Up? Revista Espanola de Quimioterapia 2023, 36, 59–63. [Google Scholar] [CrossRef]
- Matrose, N.A.; Obikeze, K.; Belay, Z.A.; Caleb, O.J. Plant Extracts and Other Natural Compounds as Alternatives for Post-Harvest Management of Fruit Fungal Pathogens: A Review. Food Biosci 2021, 41. [Google Scholar] [CrossRef]
- Gómez-Gaviria, M.; Chávez-Santiago, J.O.; Martínez-Álvarez, J.A.; Mora-Montes, H.M. Animal-Derived Therapeutic Alternatives for Candidiasis Treatment. Academia Biology 2023. [CrossRef]
- Hetta, H.F.; Ramadan, Y.N.; Al-Kadmy, I.M.S.; Ellah, N.H.A.; Shbibe, L.; Battah, B. Nanotechnology-Based Strategies to Combat Multidrug-Resistant Candida Auris Infections. Pathogens 2023, 12. [Google Scholar] [CrossRef] [PubMed]
- Nickles, M.A.; Lio, P.A.; Mervak, J.E. Complementary and Alternative Therapies for Onychomycosis: A Systematic Review of the Clinical Evidence. Skin Appendage Disord 2022, 8, 269–279. [Google Scholar] [CrossRef] [PubMed]
- Żukowska, G.; Durczyńska, Z. Properties and Applications of Essential Oils: A Review. Journal of Ecological Engineering 2024, 25, 333–340. [Google Scholar]
- Siddiqui, T.; Khan, M.U.; Sharma, V.; Gupta, K. Terpenoids in Essential Oils: Chemistry, Classification, and Potential Impact on Human Health and Industry. Phytomedicine Plus 2024, 4. [Google Scholar] [CrossRef]
- Food and Drug Administration (FDA) Generally Recognized as Safe (GRAS) Available online:. Available online: https://www.fda.gov/food/food-ingredients-packaging/generally-recognized-safe-gras (accessed on 29 August 2021).
- Parrish, N.; Fisher, S.L.; Gartling, A.; Craig, D.; Boire, N.; Khuvis, J.; Riedel, S.; Zhang, S. Activity of Various Essential Oils Against Clinical Dermatophytes of Microsporum and Trichophyton. Front Cell Infect Microbiol 2020, 10. [Google Scholar] [CrossRef] [PubMed]
- Puškárová, A.; Bučková, M.; Kraková, L.; Pangallo, D.; Kozics, K. The Antibacterial and Antifungal Activity of Six Essential Oils and Their Cyto/Genotoxicity to Human HEL 12469 Cells. Sci Rep 2017, 7. [Google Scholar] [CrossRef]
- Walasek-Janusz, M.; Grzegorczyk, A.; Malm, A.; Nurzyńska-Wierdak, R.; Zalewski, D. Chemical Composition, and Antioxidant and Antimicrobial Activity of Oregano Essential Oil. Molecules 2024, 29. [Google Scholar] [CrossRef]
- Scandorieiro, S.; Rodrigues, B.C.D.; Nishio, E.K.; Panagio, L.A.; de Oliveira, A.G.; Durán, N.; Nakazato, G.; Kobayashi, R.K.T. Biogenic Silver Nanoparticles Strategically Combined With Origanum Vulgare Derivatives: Antibacterial Mechanism of Action and Effect on Multidrug-Resistant Strains. Front Microbiol 2022, 13. [Google Scholar] [CrossRef]
- Ultee, A.; Bennik, M.H.J.; Moezelaar, R. The Phenolic Hydroxyl Group of Carvacrol Is Essential for Action against the Food-Borne Pathogen Bacillus Cereus. Appl Environ Microbiol 2002, 68, 1561–1568. [Google Scholar] [CrossRef]
- Lambert, R.J.W.; Skandamis, P.N.; Coote, P.J.; Nychas, G.-J.E. A Study of the Minimum Inhibitory Concentration and Mode of Action of Oregano Essential Oil, Thymol and Carvacrol. J Appl Microbiol 2001, 91, 453–462. [Google Scholar] [CrossRef] [PubMed]
- Orchard, A.; Van Vuuren, S.F.; Viljoen, A.M. Commercial Essential Oil Combinations against Topical Fungal Pathogens. Nat Prod Commun 2019, 14, 151–158. [Google Scholar] [CrossRef]
- Nieto, G.; Ros, G.; Castillo, J. Antioxidant and Antimicrobial Properties of Rosemary (Rosmarinus Officinalis, L.): A Review. Medicines 2018, 5, 98. [Google Scholar] [CrossRef] [PubMed]
- de Sousa, D.P.; Damasceno, R.O.S.; Amorati, R.; Elshabrawy, H.A.; de Castro, R.D.; Bezerra, D.P.; Nunes, V.R. V.; Gomes, R.C.; Lima, T.C. Essential Oils: Chemistry and Pharmacological Activities. Biomolecules 2023, 13. [Google Scholar] [CrossRef]
- Marchese, A.; Arciola, C.R.; Barbieri, R.; Silva, A.S.; Nabavi, S.F.; Sokeng, A.J.T.; Izadi, M.; Jafari, N.J.; Suntar, I.; Daglia, M.; et al. Update on Monoterpenes as Antimicrobial Agents: A Particular Focus on p-Cymene. Materials 2017, 10. [Google Scholar] [CrossRef] [PubMed]
- Cimino, C.; Maurel, O.M.; Musumeci, T.; Bonaccorso, A.; Drago, F.; Souto, E.M.B.; Pignatello, R.; Carbone, C. Essential Oils: Pharmaceutical Applications and Encapsulation Strategies into Lipid-Based Delivery Systems. Pharmaceutics 2021, 13, 1–35. [Google Scholar] [CrossRef]
- León-Buitimea, A.; Garza-Cervantes, J.A.; Gallegos-Alvarado, D.Y.; Osorio-Concepción, M.; Morones-Ramírez, J.R. Nanomaterial-Based Antifungal Therapies to Combat Fungal Diseases Aspergillosis, Coccidioidomycosis, Mucormycosis, and Candidiasis. Pathogens 2021, 10. [Google Scholar] [CrossRef]
- Iravani, S.; Korbekandi, H.; Mirmohammadi, S. V; Zolfaghari, B. Synthesis of Silver Nanoparticles: Chemical, Physical and Biological Methods; 2014; Vol. 9;
- Salem, S.S. A Mini Review on Green Nanotechnology and Its Development in Biological Effects. Arch Microbiol 2023, 205. [Google Scholar] [CrossRef]
- Durán, N.; Marcato, P.D.; Alves, O.L.; De Souza, G.I.H.; Esposito, E. Mechanistic Aspects of Biosynthesis of Silver Nanoparticles by Several Fusarium Oxysporum Strains. J Nanobiotechnology 2005, 3. [Google Scholar] [CrossRef]
- Bocate, K.P.; Reis, G.F.; de Souza, P.C.; Oliveira Junior, A.G.; Durán, N.; Nakazato, G.; Furlaneto, M.C.; de Almeida, R.S.; Panagio, L.A. Antifungal Activity of Silver Nanoparticles and Simvastatin against Toxigenic Species of Aspergillus. Int J Food Microbiol 2019, 291, 79–86. [Google Scholar] [CrossRef]
- Marcato, P.D.; Parizotto, N. V.; Martinez, D.S.T.; Paula, A.J.; Ferreira, I.R.; Melo, P.S.; Durán, N.; Alves, O.L. New Hybrid Material Based on Layered Double Hydroxides and Biogenic Silver Nanoparticles: Antimicrobial Activity and Cytotoxic Effect. J Braz Chem Soc 2013, 24, 266–272. [Google Scholar] [CrossRef]
- Scandorieiro, S.; Rodrigues, B.C.D.; Nishio, E.K.; Panagio, L.A.; de Oliveira, A.G.; Durán, N.; Nakazato, G.; Kobayashi, R.K.T. Biogenic Silver Nanoparticles Strategically Combined With Origanum Vulgare Derivatives: Antibacterial Mechanism of Action and Effect on Multidrug-Resistant Strains. Front Microbiol 2022, 13. [Google Scholar] [CrossRef] [PubMed]
- Scandorieiro, S.; Teixeira, F.M.M.B.; Nogueira, M.C.L.; Panagio, L.A.; de Oliveira, A.G.; Durán, N.; Nakazato, G.; Kobayashi, R.K.T. Antibiofilm Effect of Biogenic Silver Nanoparticles Combined with Oregano Derivatives against Carbapenem-Resistant Klebsiella Pneumoniae. Antibiotics 2023, 12. [Google Scholar] [CrossRef] [PubMed]
- Scandorieiro, S.; de Camargo, L.C.; Lancheros, C.A.C.; Yamada-Ogatta, S.F.; Nakamura, C. V.; de Oliveira, A.G.; Andrade, C.G.T.J.; Duran, N.; Nakazato, G.; Kobayashi, R.K.T. Synergistic and Additive Effect of Oregano Essential Oil and Biological Silver Nanoparticles against Multidrug-Resistant Bacterial Strains. Front Microbiol 2016, 7. [Google Scholar] [CrossRef] [PubMed]
- Bocate, K.P.; Reis, G.F.; de Souza, P.C.; Oliveira Junior, A.G.; Durán, N.; Nakazato, G.; Furlaneto, M.C.; de Almeida, R.S.; Panagio, L.A. Antifungal Activity of Silver Nanoparticles and Simvastatin against Toxigenic Species of Aspergillus. Int J Food Microbiol 2019, 291, 79–86. [Google Scholar] [CrossRef]
- Scandorieiro, S.; Kimura, A.H.; de Camargo, L.C.; Gonçalves, M.C.; da Silva, J.V.H.; Risso, W.E.; de Andrade, F.G.; Zaia, C.T.B.V.; Lonni, A.A.S.G.; dos Reis Martinez, C.B.; et al. Hydrogel-Containing Biogenic Silver Nanoparticles: Antibacterial Action, Evaluation of Wound Healing, and Bioaccumulation in Wistar Rats. Microorganisms 2023, 11. [Google Scholar] [CrossRef]
- Filipe, G.A.; Bigotto, B.G.; Baldo, C.; Gonçalves, M.C.; Kobayashi, R.K.T.; Lonni, A.A.S.G.; Celligoi, M.A.P.C. Development of a Multifunctional and Self-Preserving Cosmetic Formulation Using Sophorolipids and Palmarosa Essential Oil against Acne-Causing Bacteria. J Appl Microbiol 2022, 133, 1534–1542. [Google Scholar] [CrossRef]
- Morguette, A.E.B.; Bigotto, B.G.; Varella, R. de L.; Andriani, G.M.; Spoladori, L.F. de A.; Pereira, P.M.L.; de Andrade, F.G.; Lancheros, C.A.C.; Nakamura, C.V.; Syogo Arakawa, N.; et al. Hydrogel Containing Oleoresin From Copaifera Officinalis Presents Antibacterial Activity Against Streptococcus Agalactiae. Front Microbiol 2019, 10. [Google Scholar] [CrossRef]
- Maskan Bermudez, N.; Rodríguez-Tamez, G.; Perez, S.; Tosti, A. Onychomycosis: Old and New. Journal of Fungi 2023, 9. [Google Scholar] [CrossRef]
- Fisher, M.C.; Alastruey-Izquierdo, A.; Berman, J.; Bicanic, T.; Bignell, E.M.; Bowyer, P.; Bromley, M.; Brüggemann, R.; Garber, G.; Cornely, O.A.; et al. Tackling the Emerging Threat of Antifungal Resistance to Human Health. Nat Rev Microbiol 2022, 20, 557–571. [Google Scholar] [CrossRef] [PubMed]
- Flanagan, J.N.; Steck, T.R. The Relationship Between Agar Thickness and Antimicrobial Susceptibility Testing. Indian J Microbiol 2017, 57, 503–506. [Google Scholar] [CrossRef] [PubMed]
- Chiu, C.T.; Lai, C.H.; Huang, Y.H.; Yang, C.H.; Lin, J.N. Comparative Analysis of Gradient Diffusion and Disk Diffusion with Agar Dilution for Susceptibility Testing of Elizabethkingia Anophelis. Antibiotics 2021, 10. [Google Scholar] [CrossRef] [PubMed]
- Chung, E.; Ren, G.; Johnston, I.; Matharu, R.K.; Ciric, L.; Walecka, A.; Cheong, Y.K. Applied Methods to Assess the Antimicrobial Activity of Metallic-Based Nanoparticles. Bioengineering 2023, 10. [Google Scholar] [CrossRef]
- Scorzoni, L.; Sangalli-Leite, F.; de Lacorte Singulani, J.; de Paula e Silva, A.C.A.; Costa-Orlandi, C.B.; Fusco-Almeida, A.M.; Mendes-Giannini, M.J.S. Searching New Antifungals: The Use of in Vitro and in Vivo Methods for Evaluation of Natural Compounds. J Microbiol Methods 2016, 123, 68–78. [Google Scholar] [CrossRef] [PubMed]
- Chaftar, N.; Girardot, M.; Labanowski, J.; Ghrairi, T.; Hani, K.; Frère, J.; Imbert, C. Comparative Evaluation of the Antimicrobial Activity of 19 Essential Oils. Adv Exp Med Biol 2016, 901. [Google Scholar] [CrossRef]
- Mousavi, S.A.A.; Salari, S.; Hadizadeh, S. Evaluation of Antifungal Effect of Silver Nanoparticles against Microsporum Canis, Trichophyton Mentagrophytes and Microsporum Gypseum. Iran J Biotechnol 2015, 13. [Google Scholar] [CrossRef]
- Longhi, C.; Santos, J.P.; Morey, A.T.; Marcato, P.D.; Duran, N.; Pinge-Filho, P.; Nakazato, G.; Yamada-Ogatta, S.F.; Yamauchi, L.M. Combination of Fluconazole with Silver Nanoparticles Produced by Fusarium Oxysporum Improves Antifungal Effect against Planktonic Cells and Biofilm of Drug-Resistant Candida Albicans. Med Mycol 2016, 54, 428–432. [Google Scholar] [CrossRef]
- Leyva-López, N.; Gutiérrez-Grijalva, E.P.; Vazquez-Olivo, G.; Heredia, J.B. Essential Oils of Oregano: Biological Activity beyond Their Antimicrobial Properties. Molecules 2017, 22. [Google Scholar] [CrossRef]
- Gavahian, M.; Chu, Y.-H. Ohmic Accelerated Steam Distillation of Essential Oil from Lavender in Comparison with Conventional Steam Distillation. Innovative Food Science & EmergingTechnologies 2018, 50, 34–41. [Google Scholar] [CrossRef]
- Menichetti, A.; Mavridi-Printezi, A.; Mordini, D.; Montalti, M. Effect of Size, Shape and Surface Functionalization on the Antibacterial Activity of Silver Nanoparticles. J Funct Biomater 2023, 14. [Google Scholar] [CrossRef]
- Durán, N.; Durán, M.; de Jesus, M.B.; Seabra, A.B.; Fávaro, W.J.; Nakazato, G. Silver Nanoparticles: A New View on Mechanistic Aspects on Antimicrobial Activity. Nanomedicine 2016, 12, 789–799. [Google Scholar] [CrossRef] [PubMed]
- Gautam, S.; Das, D.K.; Kaur, J.; Kumar, A.; Ubaidullah, M.; Hasan, M.; Yadav, K.K.; Gupta, R.K. Transition Metal-Based Nanoparticles as Potential Antimicrobial Agents: Recent Advancements, Mechanistic, Challenges, and Future Prospects. Discover Nano 2023, 18. [Google Scholar] [CrossRef]
- Scandorieiro, S.; de Camargo, L.C.; Lancheros, C.A.C.; Yamada-Ogatta, S.F.; Nakamura, C. V.; de Oliveira, A.G.; Andrade, C.G.T.J.; Duran, N.; Nakazato, G.; Kobayashi, R.K.T. Synergistic and Additive Effect of Oregano Essential Oil and Biological Silver Nanoparticles against Multidrug-Resistant Bacterial Strains. Front Microbiol 2016, 7. [Google Scholar] [CrossRef]
- Scandorieiro, S.; Teixeira, F.M.M.B.; Nogueira, M.C.L.; Panagio, L.A.; de Oliveira, A.G.; Durán, N.; Nakazato, G.; Kobayashi, R.K.T. Antibiofilm Effect of Biogenic Silver Nanoparticles Combined with Oregano Derivatives against Carbapenem-Resistant Klebsiella Pneumoniae. Antibiotics 2023, 12. [Google Scholar] [CrossRef] [PubMed]
- Baid, S. Combating Antifungal Resistance Available online:. Available online: https://asm.org/articles/2022/november/combatting-antifungal-resistance (accessed on 9 July 2024).
- Chudzik, B.; Bonio, K.; Dabrowski, W.; Pietrzak, D.; Niewiadomy, A.; Olender, A.; Malodobry, K.; Gagoś, M. Synergistic Antifungal Interactions of Amphotericin B with 4-(5-Methyl-1,3,4-Thiadiazole-2-Yl) Benzene-1,3-Diol. Sci Rep 2019, 9. [Google Scholar] [CrossRef] [PubMed]
- Goudarzi, M.; Mir, N.; Mousavi-Kamazani, M.; Bagheri, S.; Salavati-Niasari, M. Biosynthesis and Characterization of Silver Nanoparticles Prepared from Two Novel Natural Precursors by Facile Thermal Decomposition Methods. Sci Rep 2016, 6. [Google Scholar] [CrossRef] [PubMed]
- LUO, X.; SEDMAN, J.; ISMAIL, A.A. Microencapsulation of Oregano (Origanum Vulgare L.), Rosemary (Rosmarinus Officinalis L.) and Sage (Salvia Officinalis L.) Essential Oils in β-Lactoglobulin. J Food Sci Technol 2019, 4, 970–985. [Google Scholar] [CrossRef]
- Pola, C.C.; Medeiros, E.A.A.; Pereira, O.L.; Souza, V.G.L.; Otoni, C.G.; Camilloto, G.P.; Soares, N.F.F. Cellulose Acetate Active Films Incorporated with Oregano (Origanum Vulgare) Essential Oil and Organophilic Montmorillonite Clay Control the Growth of Phytopathogenic Fungi. Food Packag Shelf Life 2016, 9, 69–78. [Google Scholar] [CrossRef]
- Veiga, F.F.; De Castro-Hoshino, L. V.; Sato, F.; Bombassaro, A.; Vicente, V.A.; Mendes, V.; Baesso, M.L.; Negri, M.; Svidzinski, T.I.E. Fusarium Oxysporum Is an Onychomycosis Etiopathogenic Agent. Future Microbiol 2018, 13, 1745–1756. [Google Scholar] [CrossRef]
- Murdan, S. Enhancing the Nail Permeability of Topically Applied Drugs. Expert Opin Drug Deliv 2008, 5, 1267–1282. [Google Scholar] [CrossRef]
- Baswan, S.; Kasting, G.B.; Li, S.K.; Wickett, R.; Adams, B.; Eurich, S.; Schamper, R. Understanding the Formidable Nail Barrier: A Review of the Nail Microstructure, Composition and Diseases. Mycoses 2017, 60, 284–295. [Google Scholar] [CrossRef]
- Yu, Y.Q.; Yang, X.; Wu, X.F.; Fan, Y. Bin Enhancing Permeation of Drug Molecules Across the Skin via Delivery in Nanocarriers: Novel Strategies for Effective Transdermal Applications. Front Bioeng Biotechnol 2021, 9. [Google Scholar] [CrossRef] [PubMed]
- Petrilli, R.; Lopez, R.F.V. Physical Methods for Topical Skin Drug Delivery: Concepts and Applications. Brazilian Journal of Pharmaceutical Sciences 2018, 54. [Google Scholar] [CrossRef]
- Hmingthansanga, V.; Singh, N.; Banerjee, S.; Manickam, S.; Velayutham, R.; Natesan, S. Improved Topical Drug Delivery: Role of Permeation Enhancers and Advanced Approaches. Pharmaceutics 2022, 14. [Google Scholar] [CrossRef] [PubMed]
- Agência Nacional de Vigilância Sanitária (ANVISA) Guia de Controle de Qualidade de Produtos Cosméticos: Uma Abordagem Sobre Os Ensaios Físicos e Químicos. Brasil 2008.
- Agência Nacional de Vigilância Sanitária (ANVISA) Guia de Estabilidade de Produtos Cosméticos 2004, 1. Agência Nacional de Vigilância Sanitária (ANVISA) Guia de Estabilidade de Produtos Cosméticos 2004, 1.
- Singh, M.A. The Brief Study on the Human Nail. International Journal of Innovative Research in Computer Science & Technology. 2022. [Google Scholar] [CrossRef]
- Joshi, M.; Sharma, V.; Pathak, K. Matrix Based System of Isotretinoin as Nail Lacquer to Enhance Transungal Delivery across Human Nail Plate. Int J Pharm 2015, 478, 268–277. [Google Scholar] [CrossRef] [PubMed]
- Zulu, L.; Gao, H.; Zhu, Y.; Wu, H.; Xie, Y.; Liu, X.; Yao, H.; Rao, Q. Antifungal Effects of Seven Plant Essential Oils against Penicillium Digitatum. Chemical and Biological Technologies in Agriculture 2023, 10. [Google Scholar] [CrossRef]
- Graves, J.L.; Tajkarimi, M.; Cunningham, Q.; Campbell, A.; Nonga, H.; Harrison, S.H.; Barrick, J.E. Rapid Evolution of Silver Nanoparticle Resistance in Escherichia Coli. Front Genet 2015, 5. [Google Scholar] [CrossRef]
- Neto, B.B.; Scarminio, S.L.; Bruns, R.E. Como Fazer Experimentos: Pesquisa e Desenvolvimento Na Ciência e Na Indústria; Bookman, Ed.; 4th ed.; Porto Alegre, 2010;
- Shah, V.H.; Jobanputra, A. Enhanced Ungual Permeation of Terbinafine HCl Delivered Through Liposome-Loaded Nail Lacquer Formulation Optimized by QbD Approach. AAPS PharmSciTech 2018, 19, 213–224. [Google Scholar] [CrossRef]
- Nweze, E.I.; Mukherjee, P.K.; Ghannoum, M.A. Agar-Based Disk Diffusion Assay for Susceptibility Testing of Dermatophytes. J Clin Microbiol 2010, 48, 3750–3752. [Google Scholar] [CrossRef] [PubMed]
- Clinical and Laboratory Standards Institute (CLSI) M38-A2 Reference Method for Broth Dilution Antifungal Susceptibility Testing of Filamentous Fungi 2008.
- Tullio, V.; Nostro, A.; Mandras, N.; Dugo, P.; Banche, G.; Cannatelli, M.A.; Cuffini, A.M.; Alonzo, V.; Carlone, N.A. Antifungal Activity of Essential Oils against Filamentous Fungi Determined by Broth Microdilution and Vapour Contact Methods. J Appl Microbiol 2007, 102, 1544–1550. [Google Scholar] [CrossRef]
- Hammer, K.A.; Carson, C.F.; Riley, T. V. In Vitro Activity of Melaleuca Alternifolia (Tea Tree) Oil against Dermatophytes and Other Filamentous Fungi. Journal of Antimicrobial Chemotherapy 2002, 50, 195–199. [Google Scholar] [CrossRef]
- Quatrin, P.M.; Lana, D.F.D.; Kaminski, T.F.A.; Fuentefria, A.M. Fungal Infection Models: Current Progress of Ex Vivo Methods. Mycoses 2019, 62. [Google Scholar] [CrossRef]
- Scott, A.R.E.; Filchardson, M.D. Early Events in the Invasion of the Human Nail Plate by Trichophyton Mentagrophytes; 1995; Vol. 133;
- de Oliveira, A.G.; Murate, L.S.; Spago, F.R.; Lopes, L. de P.; Beranger, J.P. de O.; Martin, J.A.B.S.; Nogueira, M.A.; Mello, J.C.P. de; Andrade, C.G.T. de J.; Andrade, G. Evaluation of the Antibiotic Activity of Extracellular Compounds Produced by the Pseudomonas Strain against the Xanthomonas Citri Pv. Citri 306 Strain. Biological Control 2011, 56, 125–131. [Google Scholar] [CrossRef]
- Dias, D.T.; Steimacher, A.; Bento, A.C.; Neto, A.M.; Baesso, M.L. Thermal Characterization in Vitro of Human Nail: Photoacoustic Study of the Aging Process. Photochem Photobiol 2007, 83, 1144–1148. [Google Scholar] [CrossRef] [PubMed]

| Fungal species | OEO (%, v/v) | REO (%, v/v) | bioAgNP (%, v/v) |
|---|---|---|---|
| Trichophyton mentagrophytes | 0.047 ± 0.02 | 0.188 ± 0.09 | 2.93×10 -3 ± 0.01 |
| Trichophyton rubrum | 0.047 ± 0.02 | 0.188 ± 0.09 | 1.46×10-3 ± 0.00 |
| Microsporum canis | 0.094 ± 0.04 | 0.188 ± 0.09 | 1.93×10-3 ± 0.00 |
| Microsporum gypseum | 0.063 ± 0.00 | 0.250 ± 0.00 | 3.90×10-3 ± 0.00 |
| Fungal species | OEO (%, v/v) | REO (%, v/v) | bioAgNP (%, v/v) |
|---|---|---|---|
| Trichophyton mentagrophytes | 0.133 | 0.250 | > 0.25 |
| Trichophyton rubrum | 0.063 | 0.125 | 8.14×10-4 |
| Microsporum canis | 0.208 | > 0.250 | > 1.95×10-3 |
| Microsporum gypseum | 0.078 | > 0.250 | > 3.91×10-4 |
| Active | CC50/72h (%, v/v) |
|---|---|
| OEO | > 7.00 |
| REO | 0.049 |
| bioAgNP | 1.33 |
Disclaimer/Publisher’s Note: The statements, opinions and data contained in all publications are solely those of the individual author(s) and contributor(s) and not of MDPI and/or the editor(s). MDPI and/or the editor(s) disclaim responsibility for any injury to people or property resulting from any ideas, methods, instructions or products referred to in the content. |
© 2024 by the authors. Licensee MDPI, Basel, Switzerland. This article is an open access article distributed under the terms and conditions of the Creative Commons Attribution (CC BY) license (http://creativecommons.org/licenses/by/4.0/).
